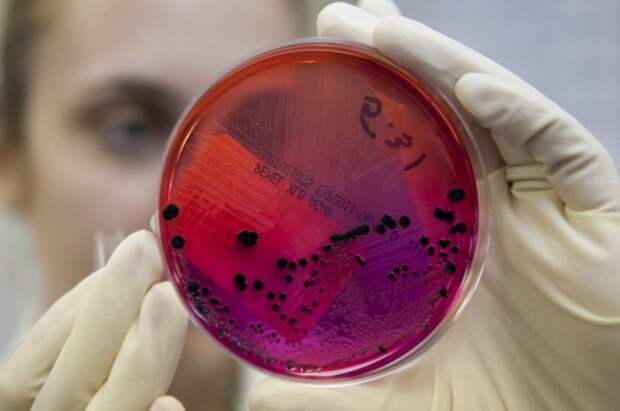

У еще одного жителя Чувашии вчера ночью появились признаки заражения бактерией сибирской язвы. Об этом сообщает «Чувашинформ» со ссылкой на Минздрав региона.
В ведомстве отметили, что медики обнаружили на ухе гражданина багрово-фиолетовое пятно с выделениями.
О первых двух случаях заражения сибирской язвой в Чувашии стало известно 15 марта. Инфекция обнаружена у жителей Цивильского округа.
Уже установлено, что источником заражения стала туша быка.В деревне Старое Акташево, где заразились первые два человека, действует карантин.
Ранее врач-эпидемиолог Геннадий Онищенко рассказал об основных путях заражения сибирской язвой.
Свежие комментарии